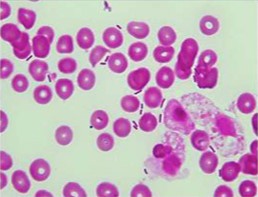
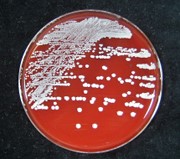

臨床検査科
科長挨拶
昨年秋より臨床検査科長を拝命致しました。坂井俊哉と申します。
専門は血液内科で、前任の病理診断科・鈴木先生の後任となります。
当院の臨床検査科は国際規格「ISO15189」の認証施設であり、ゲノム医療や腫瘍循環器病学に関連した高度な検査が提供されていることや、今年から開設されたパソロジーセンターの業務など、高度医療を支える重要部門となっております。今年は、ISOの施設訪問が終了したことから、今後は夏の病院機能評価受審に向けて、スタッフの皆さんと頑張っていきたいと考えております。
正確で質の高い検査の実施や輸血における医療安全が重要と考えていますが、昨今の状況からは、効率的な業務、継続的な技術の向上とスタッフの疲弊予防がわたくしの課題と考えております。わたくしの関心領域ですが、血液学を中心とした内科学全般のほか、最近はライフハック(働き方改革など)、マイクロバイオーム・メタゲノムシークエンス解析などに興味を持っております。
今後とも、どうぞよろしくお願いします。
臨床検査科 科長 坂井俊哉
技師長挨拶
臨床検査データは、日々の診療活動において診断の基となり、治療方針の決定に欠かせない重要な情報です。北海道がんセンター臨床検査科は、臨床検査室の国際標準規格であるISO 15189 を取得しており、標準化された品質管理と検査手法によって運営されています。この運営方式の採用により、信頼性の高い検査データを皆様に提供するとともに、がん研究や治験等にも貢献しています。
また、当検査室は、常に変化する医療のニーズに応えるべく、知識と技術の研鑽に努めています。患者様に安心していただけるよう、そして医療チームにとって信頼性の高いサポートを提供し続けられるよう、日々進化し続けることをお約束します。
臨床検査科 技師長 佐藤路生
業務内容
臨床検査科では病気の診断や治療の指針となる様々な検査データを「速く、正しく」提供することを業務としています。検査の種類や検査方法などによって、生化学、血液、免疫血清、微生物、輸血、病理、細胞診、一般検査そして生理検査の9つの部門に分かれて仕事を行っています。患者さまから採取された血液、尿、便、痰などを検査する検体検査と患者さまと直接接して行う生体検査があります。
また、緊急検査・土・日・夜間・祝祭日の検査にも対応しています。 血液検査室は造血器の悪性腫瘍(白血病、リンパ腫など)の診断のため、全自動の血液検査装置と凝固線溶測定器を備え、免疫血清・生化学検査室では最新鋭の全自動による免疫検査装置や生化学の自動分析装置を導入、感染症や各種腫瘍マーカーの検査とともに肝機能・腎機能・膵機能検査や緊急検査にも対応できるシステムが組まれています。
診療にあたる医師が患者さまの病態を正しく知り、病気の原因をさがし、 治療方法とお薬の適否を考える。 そのための情報を可及的すみやかに提供するため、病院の中に臨床検査科があります。
認定資格取得情報
2024年7月現在
| 資格名 | 人数 | |
|---|---|---|
| 日本臨床細胞学会細胞検査士 | 7人 | |
| 国際細胞検査士(IAC) | 1人 | |
| 認定病理検査技師 | 2人 | |
| 認定血液検査技師 | 2人 | |
| 認定輸血検査技師 | 1人 | |
| 認定臨床化学・免疫化学 精度保証管理検査技師 | 1人 | |
| 超音波検査士 | 消化器領域 | 3人 |
| 循環器領域 | 1人 | |
| 体表臓器領域 | 1人 | |
| 二級臨床検査技師 | 臨床化学 | 2人 |
| 免疫血清 | 2人 | |
| 血液 | 1人 | |
| 微生物 | 1人 | |
| 病理 | 1人 | |
| 緊急検査士 | 5人 | |
部門紹介
生理検査室
1.心電図検査
心臓の働きやリズムを調べる検査です。両手、両足、胸部に付けた電極から心臓の活動により発生した電位変化を記録します。不整脈,狭心症,心筋梗塞,血液の電解質異常などが分かります。また手術前検査や入院時検査としても行われます。

2.ホルター心電図検査(24時間心電図)
身体の電極とつながった小さな心電計を携帯して、一日の連続した心電図を記録する検査です。発作性の不整脈や狭心症など日常生活中での心電図変化を調べることができます。以前と比べて心電計も小さくなり、またお風呂に入ることもできるため、検査中も普段と変わらない生活を送ることができます。

3. 呼吸機能検査
肺の大きさや気管支の異常、肺のガス交換能力を調べる検査です。検査は、マウスピースを口にくわえて、「息を吸って吐いて、もっと吸って、吸って、はい止めて・・・」等の掛け声に合わせて呼吸をしてもらいます。苦痛はありませんが、ほんの少しだけ患者さんの協力が必要です。慢性気管支炎、肺気腫、肺線維症、胸郭変形などが分かります。また手術前検査としても行われます。

4. 超音波検査
体表から超音波(人間には聞こえない音波)を当てて内臓や組織の様子を調べます。超音波検査は人体に無害で痛みも伴わない安全な検査です。腹部(肝臓・胆のう・すい臓・腎臓・脾臓)、心臓、頚動脈、下肢静脈、乳腺、甲状腺などの様々な部位を調べることができます。

5. 血圧脈波検査
動脈のつまり具合や血管の硬さをみて、動脈硬化の程度を調べる検査です。検査はベッドに横になった状態で行い、両腕両足の血圧を測る3分程度の簡単な検査です。検査中に痛みや苦痛はほとんどありません。

6. 聴力検査
小さな音をどれくらい聴くことができているかを調べる検査です。ヘッドホンから流れる「ピー、ピー」という小さな音が聴こえているかどうか検査し、普段の聴覚の状態を判断します。聴力障害の原因を推定したり、難聴の種類を判断するのに必要な検査です。

7.PSG検査(睡眠時無呼吸検査)
睡眠時無呼吸症候群を診断する上で大切な検査です。検査は一泊入院して寝ている間に行います。睡眠の深さや呼吸の状態、体の動きを調べるために、患者さんの手足や頭にいくつかの電極や装置をつけた状態で一晩寝てもらい、睡眠中の様々な信号を解析して診断します。

生化学検査室
生化学検査室では、採血により得られた血液を化学的・免疫学的に分析し、疾病の診断や治療に役立てています。
主な検査内容としては、蛋白成分、電解質、糖質、脂質、腎機能、肝機能、膵機能、甲状腺機能の他、がん専門病院としての性格上、各種腫瘍マーカーの検査も行っています。
また、感染症検査(梅毒検査、HBウイルス関連、HCV抗体、HIV抗原・抗体、HTLV-1など)やHPV遺伝子検査など幅広い検査を行っています。



HbA1c分析装置 HLC-723G11(左)
血液検査室
1. 血球計数
多項目自動血球分析装置を用いて赤血球、白血球、血小板、網状赤血球、白血球5分類を迅速検査にて測定しています。
2. 血液像
自動的に血液塗抹標本を作製・染色し、目視鏡検により血液像(白血球分類・赤血球形態・血小板形態)を検査しています。
3. 凝固線溶検査
全自動血液凝固測定装置を用いて凝固検査(PT、APTT、フィブリノーゲン、AT3)や線溶検査(FDP、Dダイマー)を測定しています。


一般検査室
一般検査室では主に尿、便、髄液、穿刺液の検体を検査しています。
1. 尿の検査
尿定性検査
尿中の蛋白や糖、潜血など10項目を尿化学自動分析装置にて測定しています。
疾病の診断の補助、治療経過のモニタリングに役立てられます。
尿沈渣検査
尿中の有形成分(細胞、細菌、結晶など)を顕微鏡にて観察する検査です。
腎・尿路系の疾病、全身性の系統的疾患の補助診断、病態把握などに役立てられます。

2. 便の検査
便中に血が混じっていないかを調べる検査です。
消化管での出血、特に大腸がんのスクリーニングに有用です。
3. 髄液の検査
髄液中の細胞の数や種類、生化学的検査などを行っています。
髄膜炎、脳出血、腫瘍の浸潤などの診断に役立てられます。
4. 穿刺液の検査
体腔液(胸水、腹水、心嚢液など)中の細胞の数や種類、生化学的検査などを行っています。
輸血検査室
安全な輸血治療のために、以下のような業務をおこなっています。
1. 検査業務
血液型検査
輸血の際に必要なABO式血液型やRh式血液型の検査。
不規則抗体検査
輸血の際に必要なABO式血液型やRh式血液型の検査。
交差適合試験(クロスマッチ)
患者さんの血液と輸血される血液を反応させ、異常反応がないか、適合性を確認する検査。

2. 製剤管理業務
血液製剤管理
赤血球製剤/血漿製剤/血小板製剤などの発注から入出庫まで、血液製剤の適正な条件での保管と管理
自己血輸血
手術などで輸血が必要だと予想される場合に、予め採血し保存していた患者さん本人の血液を輸血する方法。採血された血液は専用の貯血バックにて使用日まで他の血液製剤と同様に適正に保管されます。
病理組織検査室
患者さんが病院に来院されると、適切な治療のために適切な診断が必要になります。患者さんの体より採取された病変の組織から顕微鏡用のガラス標本がつくられます。この標本を顕微鏡で観察して診断するのが病理組織検査です。
「病理組織検査」は最終診断として大きな役割を果たします。


細胞診検査室
肺がんや膀胱がんでは、痰や尿のなかにがん細胞が混じることがあります。痰や尿を顕微鏡で調べて癌細胞がいるかどうかを判断するのが細胞診検査です。子宮がん検診では、子宮頸部から細胞をこすりとって調べます。のどや乳房などにしこりがあると、細い針を刺して吸引し、とれた細胞のなかに癌細胞がいるかどうかを調べる方法もあります。

微生物検査室
ヒトに感染症を引き起こす細菌や真菌を検出するために,塗抹検査,培養検査,抗原検出検査,結核遺伝子検査を実施しています。インフルエンザ、ノロウイルスなどのウイルスについては抗原検出検査を実施しています。
微生物検査室には,感染部位(臓器)から採取された検体が届きます。細菌性肺炎や肺結核が疑われた場合には痰,急性膀 胱炎や腎盂腎炎が疑われた場合には尿,O157などが原因の細菌性腸炎やウイルス性腸炎が疑われた場合には便,その他に,血液,髄液,胸水,腹水,関節液,膿,咽頭粘液,耳漏,角膜擦過物,膣分泌物, 組織,爪など,さまざまな検体が検査対象となります。
微生物検査は時間がかかります・・・微生物検査は、血液検査のように分析器にかけて結果を出すものとは違い結果が出るまで 最小3日~最大8週間かかることもあります。
微生物検査の流れ

以上の理由により 時間がかかります。
具体的にどんなことやっているのか?
1. 塗抹検査
塗抹の「塗」とはぬる,「抹」はなでこするという意味です。塗抹検査とは検体をスライドガラスに薄く塗り広げ,自然乾燥後,メタノールで固定し,染色を行います。普通の染色はグラム染色法で行い、顕微鏡で判定します。

2. 培養検査
検体を寒天培地に塗り広げ、一晩培養します。 翌日~2日後には細菌が増殖し、コロニー(菌の集まり)を形成します。 赤い寒天培地上にある小さな白色の丸いものがコロニー(増殖した菌の集まり)です。 1つのコロニーは何万個もの細菌が集まってできています。
3. 同定・感受性検査
検菌が発育すると,培地表面に菌の塊である集落ができます。この集落を使って同定検査を行います。 感染症の原因菌と推定できる細菌が検出された場合,薬剤感受性試験を実施します。治療のために有効な抗菌薬を調べる検査です。 当検査室は同定感受性分析装置を導入しています。

4. 微生物検査室の重要な役割
近年,多くの病院で薬剤耐性菌の検出が問題になっています。耐性菌の検出や病院内感染の原因となりうる微生物の検出を,最初にキャッチできるのは微生物検査室です。私たちは,その情報を担当医と感染予防対策室に迅速かつ正確に伝える役割を担っています。幸いにも微生物検査室と感染予防対策室、感染症内科医局が隣接しているため 情報伝達を円滑に行うことを目的に、毎朝カンファレンスを行っています。